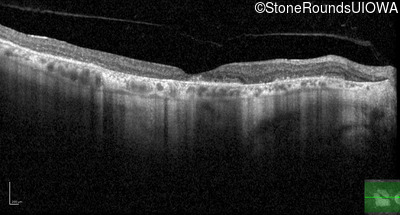
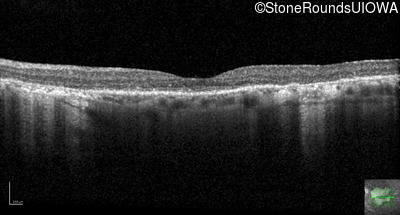

Case
SR3695
Student Mode
AR Stargardt Disease (IIA)
Male
Male
Hidden
SR3695
Student Mode
AR Stargardt Disease (IIA)
Male
Male
History
This 69 year old man had excellent vision until 7 years ago when he first noticed some difficulty in dim light especially while driving.
Diagnosis & molecular findings
| Disease | Gene | Allele 1 variant(s) | Allele 2 variant(s) | Inheritance mode |
|---|---|---|---|---|
| AR Stargardt Disease | ABCA4 | Trp1101Stop TGG>TAG | IVS30+1321 A>G | AR |
Disease:
Gene:
Allele 1:
Trp1101Stop TGG>TAG
Allele 2:
IVS30+1321 A>G
Inheritance:
AR